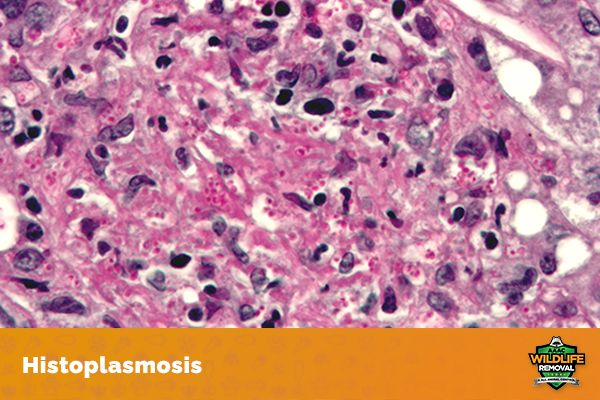

Diseases Humans Can Catch From Bird Droppings
Birds are magnificent creatures that many of us enjoy watching in our backyard or at the park. They are often seen as harmless and even friendly animals. However, what many people don't realize is that birds can actually pose a serious health risk to humans.
One of the ways birds can transmit disease is through their droppings. These droppings can contain a number of different bacteria and viruses that can cause serious illnesses in humans.
According to the Center for Disease Control (CDC), there are over 60 different zoonotic diseases that humans can contract from contact with bird feces. These diseases include everything from the common cold to more serious illnesses like meningitis and encephalitis.
The good news is that most of these diseases are relatively rare. However, it is still important to be aware of the risks associated with contact with avian droppings.
Common Diseases You Can Catch From Bird Droppings
Awareness of the risks associated with bird feces is important, especially if you work closely with birds or are exposed to their droppings on a regular basis. Here are some of the diseases:

Salmonella
Salmonella is a bacteria that can cause food poisoning. It is often found in poultry and can be transmitted to humans through contact with bird feces.
Salmonellosis is a type of food poisoning that affects the gastrointestinal tract. Symptoms of salmonella include nausea, abdominal cramps, vomiting, diarrhea, and fever. If left untreated, salmonella can lead to serious health complications such as dehydration and sepsis.
Treatment for salmonella usually involves a course of antibiotics. In severe cases, hospitalization may be necessary.

E. coli
E. coli is a bacteria that can cause a number of different illnesses, ranging from mild to life-threatening. E. coli is often found in the intestines of animals and can be transmitted to humans through contact with bird feces.
The most common illness caused by E. coli is food poisoning, which affects the gastrointestinal tract. Symptoms of E. coli food poisoning include abdominal cramps, diarrhea, and vomiting. In severe cases, E. coli can lead to kidney failure and even death.
Treatment for E. coli usually involves a course of antibiotics. In severe cases, hospitalization may be necessary.

Campylobacteriosis
Campylobacteriosis is a type of food poisoning that affects the gastrointestinal tract. It is caused by the bacteria Campylobacter. Symptoms of campylobacteriosis include abdominal cramps, diarrhea, and fever. In severe cases, campylobacteriosis can lead to dehydration and even death.
Treatment for campylobacteriosis usually involves a course of antibiotics. In severe cases, hospitalization may be necessary.

Cryptococcosis
Cryptococcosis is a fungal infection that can be caused by exposure to bird feces. It is most commonly found in pigeons and doves, but can also be found in other birds. The disease starts as pulmonary and then starts affecting the central nervous system.
Symptoms of cryptococcosis include headache, fever, and chest pain. In some cases, cryptococcosis can lead to meningitis (inflammation of the brain).
Treatment for cryptococcosis usually involves a course of antifungal medication. In severe cases, hospitalization may be necessary.

Psittacosis
Psittacosis is a bacterial infection that can be caused by exposure to bird fecal matter. It is most commonly found in parrots and other birds that are kept as pets.
Symptoms of psittacosis include headache, fever, and chest pain. In some cases, psittacosis can lead to pneumonia. Treatment for psittacosis usually involves a course of antibiotics. In severe cases, hospitalization may be necessary.
Histoplasmosis
Histoplasmosis is a serious respiratory disease caused by the fungus Histoplasma capsulatum. The fungus is found in soil and avian droppings and can be acquired by breathing in contaminated dust. The disease is especially bad for those with weakened immune systems.
Symptoms of histoplasmosis include fever, chest pain, and shortness of breath. In severe cases, histoplasmosis can lead to pneumonia or even death.
Treatment for histoplasmosis usually involves a course of antifungal medication. In some cases, hospitalization may be necessary.

Meningitis
Meningitis is a serious illness that affects the brain and spinal cord. It is most commonly caused by a viral or bacterial infection. Meningitis can be transmitted to humans through contact with fowl droppings.
Symptoms of meningitis include headache, stiff neck, and fever. In some cases, meningitis can lead to seizures, coma, and even death.
Treatment for meningitis usually involves a course of antibiotics. In some cases, hospitalization may be necessary.

Candidiasis
Candidiasis is a yeast or fungus infection that can be caused by exposure to avian droppings. Candidiasis is most commonly found in the respiratory tract. Symptoms of candidiasis include coughing, wheezing, and difficulty breathing. In some cases, candidiasis can lead to pneumonia.
Treatment for candidiasis usually involves a course of antifungal medication. In some cases, hospitalization may be necessary.

St. Louis Encephalitis
St. Louis Encephalitis is a viral infection that can be transmitted to humans through the bite of an infected mosquito. The virus is found in the droppings of infected birds and can infect humans if they come into contact with their droppings. Symptoms of St. Louis Encephalitis include headache, fever, and confusion. In some cases, St. Louis Encephalitis can lead to coma or even death.
There is no specific treatment for St. Louis Encephalitis. Treatment focuses on relieving symptoms and supporting the patient through the illness. In severe cases, hospitalization may be necessary.

Avian Influenza
Avian influenza is a viral infection that can be transmitted to humans through contact with an infected bird. Symptoms of the disease include fever, headache, and muscle aches. In some cases, avian influenza can lead to pneumonia.
There is no specific treatment for avian influenza. Treatment focuses on relieving symptoms and supporting the patient through the illness. In severe cases, hospitalization may be necessary.

West Nile Virus
West Nile Virus is a viral infection that can be transmitted to humans through the bite of an infected mosquito. The virus is found in the droppings of infected birds and can infect humans if they come into contact with contaminated avian feces. Symptoms of the virus include headache, fever, and muscle aches. In some cases, the disease can lead to coma or even death.
There is no specific treatment for this virus. Treatment focuses on relieving symptoms and supporting the patient through the illness. In severe cases, hospitalization may be necessary.
As you can see, there are many diseases that humans can catch from birds. Some of these diseases are mild, while others can be very serious. It is important to practice good hygiene and avoid contact with droppings whenever possible. If you do come into contact with bird fecal matter, be sure to wash your hands thoroughly with soap and water.
How To Protect Yourself From These Diseases?
While most diseases caused by birds can be treated, some can be deadly. It is important to be aware of the risks posed by exposure to fowl droppings and take steps to protect yourself.
Protecting yourself from diseases brought about by birds is often as simple as ensuring that you do not come in contact with them. Often, the fewer birds in the area, the less potential there is for disease.
If you must go into an area with a lot of bird feces, wear proper protective clothing including gloves, a face mask, and long sleeves.
It is also important to clean up any bird fecal matter that you come in contact with immediately to prevent the spread of disease. Be sure to wash your hands thoroughly after coming into contact with them.
In some cases, you may need to consult with a doctor if you have been exposed to the droppings and have developed symptoms of illness. Early diagnosis and treatment is important for the most serious diseases caused by birds.
By taking simple precautions, you can protect yourself from many diseases.
Here are important things to remember:
- Wash your hands thoroughly with soap and water after coming into contact with birds or their droppings
- Avoid touching your face, mouth, or eyes after coming into contact with birds or their droppings
- Clean and disinfect any surfaces that come into contact with birds or their droppings
- Wear gloves and a mask when cleaning up droppings
By following these simple guidelines, you can protect yourself from the diseases mentioned above.
If you have developed symptoms of illness after exposure, be sure to consult with a doctor as soon as possible. Early diagnosis and treatment are paramount for the most serious diseases.

Get Rid of Bird Infestation
The best way to protect yourself from diseases is to prevent them in the first place. The best way to do this is to get rid of any bird infestation on your property.
If you have birds nesting on your property, it is important to take steps to remove them as soon as possible. Leaving bird nests on your property can attract more birds and increase the risk of disease. There are a number of ways to remove birds from your property, including:
Hazing: This involves using loud noises or water hoses to scare birds away.
Habitat modification: This involves making changes to the environment that make it less attractive to birds.
Exclusion: This involves using physical barriers to keep birds from entering the area.
Professional help: In some cases, it may be necessary to hire a professional to remove birds from your property, especially if the infestation is severe.
Professional Bird Removal
If you have a serious infestation of birds on your property, it may be necessary to hire a professional to remove them. Bird removal experts can safely and effectively remove birds from your property so you won't have to worry about the dangers of birds.
If you think you may have a problem with birds on your property, be sure to contact a professional bird removal service like AAAC Wildlife Removal as soon as possible. The sooner you take action, the less risk you will face from the diseases they carry.
Final Word
Droppings from birds can carry a number of diseases that can be quite harmful to humans. And while most of these diseases are treatable if they are caught early, some can be deadly.
Awareness of these diseases and taking simple precautions can go a long way in preventing them. If you think you may have been exposed to bird fecal matter, be sure to consult with a doctor as soon as possible.
And if you have a problem with birds on your property, be sure to contact a professional bird removal service like AAAC Wildlife Removal for help. The sooner you take action, the less risk you and your family will face from any of these diseases.
Originally published on https://aaacwildliferemoval.com/blog/birds/diseases-humans-can-catch-from-bird-droppings/
Mga Komento
Mag-post ng isang Komento